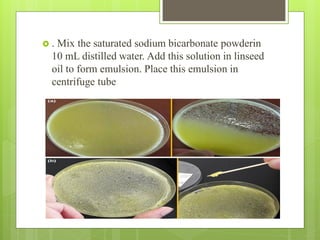
 . Mix the saturated sodium bicarbonate powderin
10 mL distilled water. Add this solution in linseed
oil to form emulsion. Place this emulsion in
centrifuge tube

This document discusses the synthesis of pesticides to kill locusts. It begins with an introduction to pesticides and describes the types including insecticides, herbicides, and fungicides. It then discusses locusts, their effects on crops, and control methods. Several chemical pesticides used against locusts are mentioned, such as dieldrin, dichlorvos, and malathion, but most were banned due to toxicity. A new effective botanical pesticide is described that uses a mixture of plant oils that kills locusts within 24 hours without harming the environment. The conclusion states this natural method is more efficient than individual oil treatments and provides over 80% control of locust populations.